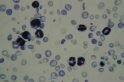

Professor Graham Brown grows malaria parasites from Papua New Guinea in a petri dish for the first time at the institute.
The introduction of this technique enables Brown and future colleagues to study the complicated and complex life cycle of this parasite in the laboratory and outside of infected individuals.
Blood-stage parasites
Prior to Brown introducing this technique, scientists had to work quickly with parasites found in blood samples supplied by patients, which were difficult to collect in sufficient quantities to undertake comprehensive research.
This achievement kick starts a vast amount of research and breakthroughs in the field of malaria at the institute. It helps to better understand this so called “blood-stage” parasites, which are responsible for most of the severe disease symptoms of malaria.
Scientists are now able to better identify possible vaccine candidates and to develop improved drugs for the treatment and elimination of malaria.
Professor Graham Brown
Despite its venerable reputation and the Nobel Prize earned by its not-long-retired director, Sir Macfarlane Burnet, few members of Graham Brown’s cohort of medicos from the University of Melbourne classes of the late 1960s and early ‘70s fancied venturing across the road to join the Walter and Eliza Hall Institute.
Like other medical students who had trained at the Royal Melbourne Hospital in that era, Brown had encountered some of the institute identities of the day, and concluded that there was little synergy between the research and clinical cultures.
A medical missionary
Not that he was a young man averse to risk. The son of a family with strong medical missionary heritage, Brown had inherited the spirit if not the theology of his forbears, and was determined to work in the developing world. “I was told I was throwing away my career – that I’d never get a job back in Australia,” Brown recalls. “I went anyway.”
He made his way to work in the medical school in Tanzania via Papua New Guinea and Nepal. He was in Africa in 1976 when he happened on a science program on the radio featuring Professor Gus Nossal, who had taken a year’s sabbatical from his post as the director of the Walter and Eliza Hall Institute to work with the World Health Organisation.
“He was talking about research on tropical diseases, and in the course of this talk he spoke of the obligation to apply the best and latest in technology to diseases of developing countries.”
Under the influence of Nossal
Returning briefly to Melbourne en route to studying public health at Harvard University, Brown mentioned to his friend John Stocker – then a PhD student at the Walter and Eliza Hall Institute, later to become Australia’s Chief Scientist – how buoyed and excited he had been by Nossal’s radio talk. “John suggested I go and see Gus.
“Gus assumed I was looking for a job,” Brown recalls. “ But I said ‘no, no – I just wanted to say that you are the first person of stature to say that my type of career choice was reasonable, and I’d like to say how much that meant to me’.”
Nossal offered to write some letters introducing Brown to his medical friends in Boston. Then one day during his Harvard stint Brown received his own letter from Nossal: “Dear Graham, I’ve been giving thought to your future. You should come and work at the WEHI.” Brown politely declined – “I’m not interested in research”.
Nossal replied: “Come anyway.”
Brown joins the immunoparasitology unit
“What I didn’t know was that he had just received a very big grant from the Rockefeller Foundation to participate in the Great Neglected Diseases of Mankind Network (1978-1988). The idea was to twin leading institutions of developed countries with partners in developing countries to bring the latest technology to the field of tropical diseases.”
So it was that at age 32 Brown began a PhD in the institute’s Immunoparasitology Unit founded and headed by Graham Mitchell. The pioneering unit sought to apply the latest discoveries in immunology to parasitology – initially schistosomiasis and leishmaniasis, and with Brown’s arrival moving into human malaria, which Brown had decided would become his focus. Before returning to Melbourne he spent some time at Rockefeller University getting a crash course on malaria parasite cultivation.
Collaboration with PNGIMR
Mitchell’s unit enlisted the Rockefeller funding to go to where the parasites were, partnering with the Papua New Guinea Institute of Medical Research (PNGIMR) in a collaboration that endures to this day.
Brown and his colleagues worked around Madang, collecting parasites and blood samples from populations who had long lived with– or could die from malaria. Children and pregnant women were particularly vulnerable, and were the focus of much of the research.
Working in Papua New Guinea
These were demanding, draining, and always exhilarating excursions. The teams used wit and imagination to work with colleagues of PNGIMR to overcome formidable cultural, scientific, environmental and bureaucratic hurdles.
They improvised with cling wrap and cardboard to create a still air cabinet for culturing parasites, or nursed them in candle jars.
They navigated their way across international borders with blood samples, dry ice, isotopes and precious collections of viable parasites.
They sweated in boiling conditions in a tropical field laboratory where they could have no breeze for fear of contaminating their experiments.
Studying the immune response to malaria parasites
Brown enjoyed collaborating with institute colleagues.
Robin Anders – “a fantastic protein chemist” – was pioneering new techniques for studying the human immune response to malaria parasites. Molecular biologist Dave Kemp – “one of the smartest people I have ever met” – developed gene expression libraries. By screening samples against antibodies from the serum of infected individuals they were able to identify proteins being made in the laboratory that could potentially be included in vaccines. (Kemp, a passionate musician, named his jazz band the “Tandem Repeats”, after a quirk in the signature of some of the malaria antigen genes he discovered.)
“I had hated biochemistry in medical school, and yet here I was doing biochemical research to analyse malaria proteins,” Brown says. “We were at the forefront of technology and encouraged to think globally at the cutting edge of international science.
A motivating environment
“With the leadership and role models of people like Gus and Jacques Miller and Don Metcalf you aspired to excellence – these were all people who could have taken on positions anywhere in the world, but they wanted to make it in Australia. We worked really hard and we loved it, surrounded by the most fantastically supportive environment.”
It was very much a multi-disciplinary collaboration, with Brown often the only clinician in the picture. “My clinical input was valued, just as I valued the protein chemists and the molecular biologists. We were getting papers in the best journals in the world on the basis of the science.”
Brown’s key discoveries
Brown ventures that his most significant contributions to the research were in linking “the bench to the bush” and with Beverley-Ann Biggs – “an excellent PhD student” – proving that parasites could vary the molecules on their surface to escape an immune response.
“We also showed that when the molecules change, they can bind differently, for example allowing the infected cells to ‘stick’ in the circulation of spleen, brain, or placenta. Stephen Rogerson, another highly talented PhD student, identified the site for binding in the placenta, an important link in understanding how malaria can cause serious problems in pregnancy.“
A successful vaccine trial
Cloning and expression of malaria antigens in E.coli was a major triumph of the unit that stimulated commercial collaboration with Hoffman LaRoche and Biotechnology Australia and eventually resulted in successful human vaccine trials in Papua New Guinea in collaboration with a team at PNG IMR led by Dr Blaise Genton.
“The highlight was getting to the field vaccine trial and showing some effect,” Brown recalls. “The disappointment was that it wasn’t considered good enough to proceed to further development.
“There was a question as to how far an organisation like the Hall Institute, whose strength is in basic science, should go down the development path. Notably those were early days of engagement with industry.
“I take my hat off to Robin Anders, the major driver of the project. We broke a lot of barriers, particularly as this type of vaccine had not been seen before.”
Promotion to Unit Head
After the departures of Mitchell and Kemp, Brown took over as unit head, overseeing the evolution of a new generation of stellar talent, among them Alan Cowman[JC5] , Simon Foote, Louis Schofield and Brendan Crabb.
While at the Walter and Eliza Hall Institute, Brown continued in a clinical role at Royal Melbourne Hospital and established the Victorian Infectious Diseases Service. He left the institute in 1999 to take up the James Stewart Chair of Medicine at the University of Melbourne. He later became founding director of the Nossal Institute for Global Health.
“There was no place at the Hall Institute for second rate science. The goal was to be at the cutting edge of world science and you had to do it well. The toughest seminar you ever gave was the one at home base.”
An advocate for careers in research
He cherishes his years at the institute and the defining training and friendships it delivered – “you can take the boy out of WEHI, but you can’t take WEHI out of the boy”.
He often urges medical students to consider spending some time dedicated to research, explaining that “you might go back to clinical work, but you will be a better doctor, a better thinker, a more critical analyst, and you will make a greater contribution to evidence-based practice”.